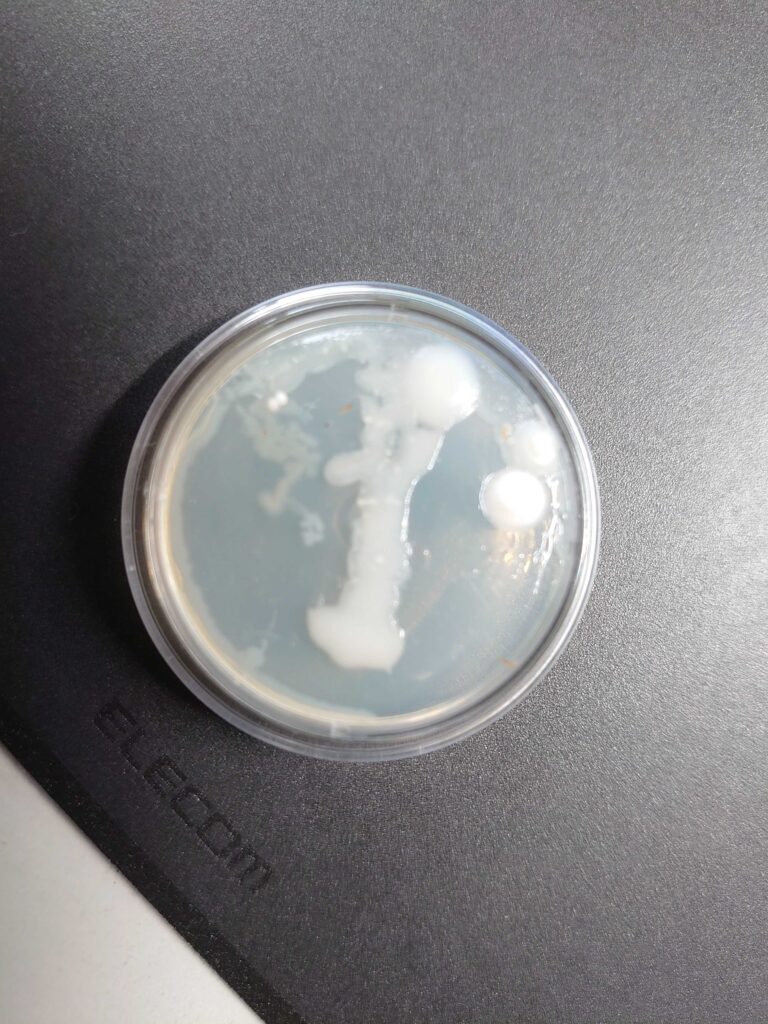

床下に水が溜まってしまったら
北海道でもここ数年大雨による床下浸水がちょこちょこ発生しているようです。
床下浸水で火災保険の適用になるには(契約内容などで変わりますが)、一般的には以下のようなルールがあると言われています。
- 床上浸水であること
- 地盤面から45cmを超える浸水により損害が生じたこと
- 建物や家財に保険価額の30%以上の損害が生じたこと
このため、単なる床下浸水では保険の対象外となることが多いです。ただし、地盤面からの浸水が45cmを超えれば、床上浸水に至っていなくても補償の対象となります。 ここで注意が必要なのが「地盤面」というのは皆さんの住宅の床下点検口を開けて見える地面のことではなくて、住宅の基礎の一番低いところって解釈なので見た目よりも深い所から測って45センチってことですね。
根入れ深さの基準:
- ベタ基礎: 地盤面から12cm以上
- 布基礎: 地盤面から24cm以上
凍結深度の考慮:
- 寒冷地など、冬に地面が凍結する可能性がある地域では、基礎の底が地面の凍結深度よりも深くなるように設計する必要があります。これは、地面が凍って膨張する「凍上」によって基礎が持ち上げられたり、建物がゆがんだりするのを防ぐためです。
とりあえず、大雨時は床下点検口の蓋をこまめに開けて点検し、水が溜まっていれば定規やメジャーなどを使って、水位が分かる写真を撮影しておく。床上浸水まで被害が拡大した場合は濡れた家財などの写真をたくさん撮影しておくなどの対策を行うのが理想的だと思います。
床下に水がたまった場合自然に水位が下がるのを待っても大丈夫か?
ベタ基礎(床下全部がコンクリートの床みたいになっているタイプの基礎)の場合は、自然に水位が下がるというのはなかなか難しく、ポンプなどで強制的に水を抜かなければいけない場合が多いです。
布基礎(床下が砂利になっているタイプの基礎)この場合は自然に水位が下がることも多いです。
ただ、どちらのタイプの基礎にしても水が一度溜まってしまうと人為的に乾燥させたりカビ処理を行わなければ床下がカビだらけになってしまうことが多いです。


先週施工した現場の床下写真ですが、大雨の直後で床下に水が溜まっています。
この時点で床下はかなりの量のカビが発生していました。
僕がすっかり虜になっているユーチューバーの「大工の正やん」って大工さんも「住宅は基礎が一番大事」って言ってましたが、やはり基礎がカビたり湿気ると住宅としては良いことは一つもありません。
化学的に考えても、一般的な乾燥空気の平均分子量は28.8程度と言われています。湿気を含んだ空気の平均分子量は18程度と考えられており、乾燥空気よりも軽いため上へ上へと上昇します。
住宅の床下が湿った場合湿り空気は住宅の上の方、すなわち居住空間へと上がってきて、壁の裏のカビの原因、それが酷くなり目に見える個所がカビだらけになる、などなど住宅がカビにより致命的なダメージを受ける原因になります。
床下のカビ対策


右の写真の白いフカフカは全てカビです。左の写真は床下にオゾンガスを充満させるための送風処理。
未だに建築のプロの間でも「乾かせば大丈夫」という誤った認識が広く根付いていますが、近年の研究ではなんらかの処理を行わなければ乾燥だけでは住宅のカビ被害は拡大する。という研究結果も出てきています。
保険対応が可能でも難しくても、住宅を長持ちさせたい、カビによる健康被害が心配、などなど建物とそこに暮らす人々の健康を優先するのであればなんらかの対策が必須になってくると思われます。
ここで注意が必要なのが、床下を乾燥させて防カビ剤を噴霧するだけとかでは効果が限定的であるという点です。
防カビ剤はあくまでも防カビ効果しか持ちませんので、現状発生しているカビ菌には有効な成分は含まれていません。
また、薬剤噴霧では空間に浮遊するカビ菌への効果は限定的ですので、地面や壁面は処理したのに、時間経過で浮遊菌が再度付着してカビが再発。なんていう残念な現象も起こりかねません。
同時にカビの菌数測定なども行うことが理想的です
ルミテスターという綿棒で対象個所を拭き取り機械に綿棒を入れるとバイキンの数が数値化される機械。これも有効ではありますが、ルミテスターですとカビだけを測定することは出来ません。
新型コロナウイルスが大流行していたときに、抗菌コーティングの施工業者さんが「施工後はルミテスターで測定」なんて馬鹿げたことを言っていて、騙される人が多かったですが、ルミテスターは菌数は調べられても、ウイルスは調べられません。新型コロナウイルス。ですから菌ではない。。。。なんて余談でした(笑)
カビを調べるにはカビ専用の装置で菌を採取、その後培養して調べる必要があります。
空中に浮遊する菌の数、特定の個所に付着しているカビの数、できれば施工前後で調べると安心です。
カビ処理って目に見えない作業ですからデータ化して目に見える評価を行いたいところですよね。

床下って普段見る機会はほとんどありません。
床下点検口の蓋の部分ってゴミも溜まりやすいですし、お掃除をするという意味合いも含ませ、定期的に床下点検口を開けてお掃除ついでに床下の状況をチェックする習慣をつけることをお勧めします。
ここ最近の大雨で床下に水が溜まっている住宅、意外と多いかもしれません。
あと悲しいのが、新築なのに排水管がきちんと接続されておらず床下が汚水のプールとか。。。。
時々覗いてみるがいいですね。


コメント